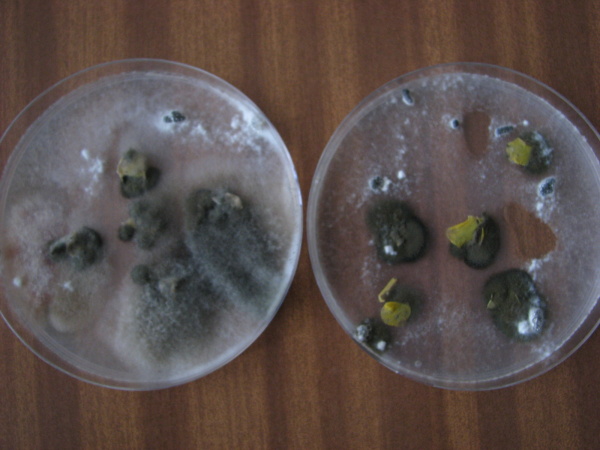
V&yacute;skyt bielej hniloby v&nbsp;porastoch repky na z&aacute;klade progn&oacute;zy pomocou infekcie kvetn&yacute;ch lupienkov v&nbsp;tomto roku bude pravdepodobne n&iacute;zky. Len minim&aacute;lne množstvo lupienkov bolo infikovan&yacute;ch a&nbsp;po naložen&iacute; na umel&uacute; živn&uacute; p&ocirc;du z&nbsp;nich vyr&aacute;stlo myc&eacute;lium huby Sclerotinia sclerotiorum a&nbsp;skler&oacute;ci&aacute;.

Výskyt chorôb a škodcov repky ozimnej v sezóne 2011/2012 a možnosti ochrany
30. 07. 2012 Ochrana obecně Zobrazeno 7792x
Ozimná repka v tomto roku odkvitla pomerne rýchlo, kvitnutie trvalo 3–4 týždne, čo je oproti minulým rokom o 1–2 týždne kratšie. V čase písania tohto príspevku (polovica mája) sú už väčšinou porasty repky ozimnej odkvitnuté, v rastovej fáze dozrievania. Zdravotný stav porastov je v tomto období dobrý, bez výraznejšieho výskytu chorôb. Na vývoji a kondičnom stave repky v tejto sezóne 2011/2012 sa však výrazne negatívne podpísali nepriaznivé poveternostné podmienky. Už na jeseň pri zakladaní porastov, najmä v oblasti juhozápadného Slovenska, spravilo škrt cez rozpočet pestovateľom veľké sucho. Zasiate porasty ozimnej repky vzchádzali len veľmi slabo, pomaly a niekde nevzišli vôbec. Najviac bola extrémne suchou jeseňou postihnutá najmä oblasť levického okresu.
V porovnaní s Českou republikou, kde boli porasty repky ozimnej na jeseň v ideálnom stave, na Slovensku boli porasty väčšinou riedke a nízke. Porasty, ktoré vzišli museli prekonať na mnohých miestach aj nepriaznivé holomrazy, bez snehovej pokrývky v období od konca januára do druhej polovice februára. Pri holomrazoch dosahovala teplota bežne -15 °C až -20 °C. Pôda premŕzala asi do hĺbky 50 cm. Mráz v kombinácii s hubovými chorobami, najmä s fómovou hnilobou, spôsobili poškodenie koreňovej kôry repky a zastavenie prívodu živín do rastliny. Z približne 160 tis. ha, na ktorých bola repka zasiata, asi 25 % nevzišlo a 25 % vyzimovalo. Extrémny priebeh počasia pokračoval aj v jarnom období s minimálnymi, alebo žiadnymi zrážkami až do apríla. Nedostatok zrážok však výrazne obmedzil prísun živín z aplikovaných hnojív ku koreňom rastlín. Toto oneskorené prijímanie živín, rovnako ako aj poškodenie repky zimnými mrazmi a suchom sa určite negatívne prejaví na dosiahnutej úrode semena.
Sucho, s minimálnymi zrážkami, ktoré v tomto období prevláda na západnom Slovensku nie je vhodné pre rozšírenie niektorých dôležitých chorôb repky ako je biela hniloba. Avšak prípadne dlhšie obdobie so zrážkami môže situáciu výrazne zmeniť. Škodlivosť bielej hniloby, ktorú spôsobuje hubaSclerotinia sclerotiorum, môže byť veľmi vysoká a zníženie úrod v niektorých rokoch s epidemickým výskytom môže dosiahnuť aj 50%. Priame straty na úrode závisia najmä od miery napadnutia a stupňa poškodenia rastlín. Približne je možné straty stanoviť ako polovica z celkového percenta napadnutých rastlín. Teda v prípade ak sa v poraste zistí 20 % napadnutých rastlín, predpokladaná strata na úrode je orientačne 10 %. K najnápadnejším príznakom ochorenia patrí vädnutie a núdzové dozrievanie rastlín, viditeľné v čase dozrievania. Na stonkách sa tvoria hnedé škvrny, ktoré sa môžu rozširovať po obvode stonky, čo môže spôsobiť odumieranie rastlín. V období kvitnutia je aktuálna askospórová infekcia, pri ktorej sú rastliny repky v období kvitnutia infikované askospórami huby. Askospóry sa tvoria v plodničkách - apotéciách, ktoré vyrastajú vo vhodných podmienkach na skleróciách. Skleróciami patogén prežíva v pôde veľmi dlhé obdobie. Ak sa nachádzajú v povrchových vrstvách, tak pri vyššej vlhkosti pôdy, teplote pôdy 15–20 °C a teplote vzduchu 20–25 °C sa môžu na nich vytvoriť apotéciá. Askospóry uvoľnené z apotécií sú prenášané vetrom aj do vzdialenosti niekoľko km. Askospóry infikujú kvety, prípadne stonky. Vhodným substrátom, na ktorom askospóry rýchlo klíčia, je veľké množstvo opadnutých kvetných lupienkov zachytených na rastline. Vznik infekcií a rozvoj ochorenia podporuje daždivé počasie najmä v čase opadávania kvetných lupienkov.
Práve fakt, že askospóry patogéna Sclerotinia sclerotiorum začínajú klíčiť na opadnutých kvetných lupienkoch sa využíva pri prognóze a signalizácii výskytu bielej hniloby. K diagnostike výskytu bielej hniloby je možné použiť aj rastlinné indikátory, napríklad jarnú repku, ktorá v našich podmienkach prezimuje a kvitne skôr ako skoršie odrody repky ozimnej. Diagnostika a prognóza výskytu bielej hniloby je založená na izolácii patogéna z opadnutých kvetných lupienkov, ktoré sa nakladajú na agarovú živnú pôdu v petriho miskách. V prípade, ak sú askospóry huby prítomné na lístkoch, vyrastie na agarových platniach biele mycélium patogéna. Kultivácia trvá týždeň pri teplote 20 °C. Na základe počtu infikovaných kvetných lupienkov je možné predpovedať potenciálný infekčný tlak patogéna a riziko výskytu bielej hniloby v porastoch repky. Pri zistení menej ako 45 % infikovaných kvetných lupienkov (nízka infekcia) je možné očakávať do 20 % napadnutých rastlín v poraste, pri počte 45–90 % infikovaných lupienkov (stredná infekcia) sa predpokladá napadnutie rastlín v poraste 20–40 %. Pri viac ako 90 % infikovaných lupienkoch (silná infekcia) môže byť v porastoch napadnutých viac ako 40 % rastlín.
Dôležitým faktorom v procese vývoja bielej hniloby sú poveternostné podmienky. Z hľadiska prognózy výskytu bielej hniloby je dôležité sledovať najmä teploty a zrážky pred začiatkom kvitnutia. Práve vlhkostné podmienky v tomto období ovplyvňujú tvorbu apotéciá a askospór. Ak pred kvitnutím pretrváva daždivé počasie a pokračuje aj na začiatku kvitnutia existuje vysoké riziko rozšírenia bielej hniloby.
Fungicídne ošetrenie proti bielej hnilobe je potrebné vykonať v období kvitnutia včas, v závislosti od priebehu počasia. Optimálny termín aplikácie fungicídov je začínajúce opadávanie kvetných lupienkov. Posledným možným termínom fungicídnej ochrany porastov repky proti patogénom infikujúcim šešule je rastová fáza dokvitania (kvitne už iba 10 % vrchných kvietkov). V prípade oneskoreného použitia fungicídu (po štádiu keď kvitne viac ako 50 % kvetov) sa účinnosť ochrany výrazne znižuje. Na ochranu proti bielej hnilobe môžeme použiť fungicídy na báze účinných látok carbendazim, difenoconazole, tebuconazole, iprodione, prochloraz, vinclozin a ďalšie.
 |
| Poškodenie koreňového krčka rastliny repky |
 |
| Odumretie koreňového krčka a nadzemnej časti repky v dôsledku výskytu fómovej hniloby na koreňovom krčku |
 |
| Fómové poškodenie strednej časti koreňového krčka a koreňa repky |
Stále častejšie sa v porastoch repky vyskytuje verticíliové vädnutie, spôsobené hubami z rodu Verticillium. Tieto patogénne organizmy prenikajú cez korene do cievnych zväzkov, produkujú mykotoxíny, zastavujú prívod vody a živín do rastlín, čo spôsobuje ich núdzové dozrievanie. V povrchových pletivách napadnutých rastlín sa tvoria mikroskleróciá, ktoré môžu v pôde prežívať i viac ako 10 rokov. Ošetrenie prípravkami obsahujúcimi účinnú látku azoxystrobin v štádiu žltého púčika až do začiatku kvitnutia účinkuje nielen proti bielej hnilobe, ale môže čiastočne pôsobiť aj proti patogénom spôsobujúcim verticíliové vädnutie. V mnohých zahraničných pokusoch takéto ošetrenie malo vplyv aj na zvýšenie úrod repky (green efect).
Po prezimovaní repky, najmä na rastlinách na jeseň poškodených siaticou oziminovou alebo kvetárkou kapustovou, sa mohla objaviť aj fómová hniloba koreňov a stonky. Taktiež oslabené rastliny po neskorom vzchádzaní počas suchej jesene a po tuhých mrazoch v januári s poškodenými koreňovými krčkami, ktoré boli popraskané, s výrazne poškodeným epidermisom, môžu byť ľahko infikované rôznymi patogénmi. Vhodné podmienky pre napadnutie rastlín sú aj na lokalitách s vyššou snehovou pokrývkou, kde sa môžu rozvíjať najmä pleseň sivá a fómová hniloba koreňov repky. Pri prehliadkach porastov repky na jar po prezimovaní sme na niektorých lokalitách zistili aj poškodenie strednej časti pletív stonky, narušenie cievnych zväzkov a tiež aj úplné odhnitie nadzemnej časti repky. V takomto prípade je potrebné vhodnými ochrannými opatreniami (fungicídne ošetrenie) zastaviť rozvoj ochorenia, ktoré môže viesť až k úplnému rozrušenie koreňového krčka a spôsobiť poliehanie rastlín. Chemickú ochranu porastov repky je možné robiť účinnými fungicídmi. V tomto období je možné využiť aj morforegulačný účinok niektorých prípravkov, čo podporí vetvenie rastlín.
Infekčný tlak chorôb chorôb na jar je možné výrazne znížiť aj zabránením poškodeniu stoniek rastlín škodcami, najmä krytonosmi, ktorý poškodzujú stonky rastlín a uľahčujú tak prenikanie patogénnych organizmov (Botrytis cinerea, Phoma lingam, Alternaria spp. a pod.).
K najdôležitejším škodcom repky ozimnej na jar patria krytonosy. Krytonos repkový a krytonos štvorzubý sa začínajú objavovať v porastoch repky už pri prvom oteplený, skoro na jar. Imága krytonosa repkovéhonalietavajú na porasty repky skoro na jar a živia sa vyžieraním drobných dierok do listov a stoniek. Samičky následne kladú vajíčka do hornej časti stonky, kde sa vytvárajú tenké ryhy a neskôr dochádza k deformáciám rastliny a ich zaostávaniu v raste. Vyliahnuté larvy vyžierajú stržeň stoniek, rastliny trpia nedostatočným prívodom živín a dávajú semená nižšej kvality. Poškodenie stoniek umožňuje napadnutie rastlín hubovými chorobami (Phoma sp. a Verticilium sp.). Larvy opúšťajú rastlinu a kuklia sa v pôde. Krytonos repkový môže pri veľkom napadnutí znížiť úrodu až o 50 %. Krytonos štvorzubýspôsobuje menšie škody, v porovnaní s krytonosom repkovým, pretože po poškodení nedochádza k deformáciám stoniek a nalietava neskôr.
V tomto roku bol na žltých lapačoch zaznamenaný maximálny počet krytonosov (60–80 imág) na západnom Slovensku už v poslednej dekáde marca. V ďalších týždňoch už bol výskyt zachytených imág minimálny (2–3 imága). Chemickú ochranu proti krytonosom je potrebné vykonať predtým ako samičky nakladú vajíčka. Ošetrenie sa má urobiť na začiatku náletu imág, (v tomto roku to malo byť koncom marca) v závislosti od teploty. Nálet imág je vhodné sledovať pomocou žltých misiek (Mörickeho misky) alebo žltých lepových pásov. Prahom škodlivosti je 6 imág za 3 dní priemerne na jednu misku alebo 2 imága za rovnaké obdobie na jeden lepový pás alebo 1 imágo na 40 rastlín. Na ochranu sú registrované pyretroidy, kombinácie organofosfátov a pyretroidov a systémové neonikotinoidy. Ak boli ošetrenia urobené neskôr znižuje sa ich účinnosť.
Z preventívnych ochranných opatrení proti stonkovým krytonosom je dôležitá priestorová izolácia a nepestovanie repky v blízkosti porastov kapustovej zeleniny. Veľký význam má tiež likvidácia pozberových zvyškov po kapustovej zeleniny a ničenie kapustovitých burín. V prípade silného napadnutia porastov repky krytonosmi je účinná hlboká orba po zbere, pri ktorej sa premiestnia škodca do väčšej hĺbky a výrazne sa zníži množstvo prezimovaných imág. Prezimovanie škodcu je výrazne ovplyvňované najmä poveternostnými podmienkami v zime a začiatkom jari. Vysoký obsah vody v pôde (povodne, časté zrážky) môžu výrazne znížiť početnosť krytonosov v jarnom období, ako tomu bolo napríklad na jar v roku 2011, keď v roku 2010 padli veľké množstvá zrážok. Suché podmienky sú vhodné pre prezimovania krytonosov a aj preto bol v tomto roku vyšší výskyt krytonosov v porastoch repky na jar.
 |
| Veľké množstvo stonkových krytonosov (cca 80) chytených na žltom lapači 27. 3. O týždeň neskôr bolo chytených už len niekoľko jedincov (2 – 3) krytonosov. |
 |
| Rastlina repky po poškodení krytonosom. Krytonos repkový, ktorý kladie vajíčka pod vegetačný vrchol a do vrchnej časti stonky je škodlivejší, lebo stonky sa deformujú do písmena S. |
|
| Výskyt bielej hniloby v porastoch repky na základe prognózy pomocou infekcie kvetných lupienkov v tomto roku bude pravdepodobne nízky. Len minimálne množstvo lupienkov bolo infikovaných a po naložení na umelú živnú pôdu z nich vyrástlo mycélium huby Sclerotinia sclerotiorum a skleróciá. |
 |
| Deformáciu stoniek po napadnutí stonkovými krytonosmi je vidieť aj v období kvitnutia repky |
 |
| Po prerezaní deformovaných stoniek sa v nich nachádza niekoľko lariev krytonosa |
K ďalším významným škodcom repky patrí aj blyskáčik repkový. Chrobáky na repku začínajú prelietavať v období tvorby kvetných púčikov, vžierajú sa do pukov a živia sa výlučne peľom. Ak naletia na repku v štádiu tvorby púčikov dochádza k poškodeniu kališných lístkov a semenníkov. Poškodené púčiky žltnú, zasychajú a neskôr opadávajú, pričom na súkvetí ostávajú iba kvetné stonky čo dáva súkvetiam nepravidelný vzhľad. Keď už repka kvitne, žer imág nespôsobuje takmer žiadne škody. V tomto roku nebol pozorovaný vysoký počet imág blyskáčika repkového a rovnako škodlivosť nebola veľká. Chemická ochrana sa uskutočňuje ak zistený výskyt škodcu na porastoch dosiahne prah škodlivosti. V štádiu zelených púčikov je prah škodlivosti 1 chrobák na 1 súkvetie. V tomto období je možné len okrajové ošetrenie parciel do hĺbky 50–100 m. V štádiu pred kvitnutím a na začiatku kvitnutia je prah škodlivosti 2–3 chrobáky na súkvetie. Počet imág sa zisťuje na piatich súkvetiach vedľa seba na 20 miestach. Zvlášť sa hodnotí okraj porastu a zvlášť stred. Ak teploty presiahnu 12 °C hodnotenie je treba robiť v ráno alebo podvečer. Aj porasty repky je nutné ošetrovať ráno prípadne podvečer.
Ochranné opatrenia vykonané v tomto období účinkujú aj proti krytonosovi šešuľovému. Samičky krytonosa kladú po jednom vajíčku do šešúľ a pred kladením vyhrýzajú do šešúľ malé dierky. Tieto poškodenia uľahčujú kladenie vajíčok do šešúľ byľomorovi kelovému. Napadnuté šešule sú len trochu zdurené, svetlejšie, nepraskajú a ťažko ich odlíšiť od zdravých. Škodlivosť tohto krytonosa je oproti byľomoru ďaleko menšia. Šešule sa neotvárajú a larva obvykle zničí „len“ 3–6 semien v jednej šešuli a to sa na úrode i pri veľkom napadnutí až tak veľmi neprejaví.
Najvýznamnejším šešuľovým škodcom repky je byľomor kelový. Samičky kladú vajíčka do malých, tvoriacich sa šešúľ (dlhých 2–3 cm) so slabými stenami a do šešúľ mechanicky poškodených hmyzom (krytonosom šešuľovým, skočkami, bzdôškami). Samičky kladú najčastejšie 10 vajíčok. Do jednej šešule môže naklásť vajíčka aj niekoľko samičiek takže v jednej šešuli sa môže vyvinúť aj 100 lariev. Larvy škodia cicaním vnútorných stien šešúľ a semien, pričom vylučujú toxické látky spôsobujúce žltnutie, sfialovenie, deformáciu a zdurenie šešúľ. Napadnuté šešule predčasne praskajú a vypadávajú z nich semená. Najviac bývajú poškodené okraje porastov kde môže byľomor spolu s krytonosom šešuľovým spôsobiť straty na úrode aj 50 %. Aj pri bežnom napadnutí v každom roku predstavujú straty v priemere 7 %. V roku 2011 bola jeho škodlivosť veľmi malá, lebo po extrémne daždivom roku 2010 bol vodou veľmi zdecimovaný. V tomto roku je možné predpokladať vyššie výskyty byľomora a tiež väčšie poškodenia porastov. Chemická ochrana sa mala vykonať ak bol prekročený prah škodlivosti škodcu od fázy žltého púčika do konca plného kvitnutia. Prahom škodlivosti je 1 samička byľomora na 4 rastliny. Pri hodnotení výskytu metódou smýkania je prah škodlivosti 2 byľomory na 10 smykov.
V súčasnosti už boli všetky ochranné opatrenia realizované a nám ostáva len dúfať, že priebeh počasia bude aspoň v období dozrievania repky ozimnej priaznivejší, so zrážkami, bez vyšších denných resp. nočných teplôt, ktoré môžu byť príčinou výraznejšieho zasychania šešúľ a spôsobiť ešte vyššie straty na úrode semien.
 |
| Šešuľa poškodená byľomorom kelovým |
 |
| Množstvo lariev byľomora kelového v poškodených šešuliach repky môže spôsobiť značné škody |
| Tab. 1: Prehľad chemických prípravkov proti chorobám repky uvedených v Zozname registrovaných prípravkov na ochranu rastlín pre rok 2012 | |||||
|
Prípravok
|
Účinná látka
|
biela hniloba
|
pleseň sivá
|
fómová hniloba
|
alternáriová škvrnitosť
|
|
Amistar Xtra
|
azoxystrobin + cyproconazole
|
x
|
|||
|
Cantus
|
boscalid
|
x
|
|||
|
Pictor
|
boscalid + dimoxistrobin
|
x
|
x
|
x
|
|
|
Alert xtra
|
carbendazim + epiconazole
|
x
|
|||
|
Harvesan
|
carbendazim + epiconazole
|
x
|
|||
|
Alert S
|
carbendazim + flusilazole
|
x
|
|||
|
Sportak alpha HF
|
carbendazim + prochloraz
|
x
|
x
|
||
|
Capitan 25 EW
|
flusilazole
|
x
|
|||
|
Version
|
flusilazole
|
x
|
|||
|
Caramba
|
metconazole
|
x
|
x
|
x
|
|
|
Prosaro 250 EC
|
prothioconazole + tebuconazole
|
x
|
x
|
x
|
x
|
|
Horizon 250 EW
|
tebuconazole
|
x
|
x
|
||
|
Lynx
|
tebuconazole
|
x
|
x
|
||
|
Q-bucon
|
tebuconazole
|
x
|
x
|
||
|
Tebulam 250 EW
|
tebuconazole
|
x
|
x
|
||
|
Orius 25 EW
|
tebuconazole
|
x
|
x
|
||
|
Caryx
|
metconazole + mepiquatchlorid
|
x
|
|||
|
Riza
|
tebuconazole
|
x
|
x
|
||
|
Sparta
|
tebuconazole
|
x
|
x
|
||
|
Toprex
|
difenolconazole + paclobutrazol
|
x
|
|||
|
Tab. 2: Prehľad chemických prípravkov proti škodcom repky uvedených v Zozname registrovaných prípravkov na ochranu rastlín pre rok 2012 |
||||||
|
Prípravok
|
Účinná látka
|
Krytonos repkový
|
Krytonos štvorzubý
|
Krytonos šešuľový
|
blyskáčik repkový
|
byľomor kelový
|
|
Mospilan 20 SC
|
acetamiprid
|
x
|
x
|
x
|
x
|
x
|
|
Vaztak 10 EC
|
alpha-cypermethrin
|
x
|
x
|
x
|
||
|
Bulldock 25 EC
|
beta-cyfluthrin
|
x
|
x
|
x
|
||
|
Cyperkill 25 EC
|
cypermethrin
|
x
|
||||
|
Cythrin
|
cypermethrin
|
x
|
||||
|
Cyprin 10 EC
|
cypermethrin
|
x
|
||||
|
Nurelle D
|
cypermethrin + chlorpyriphos
|
x
|
x
|
|||
|
Decis EW 50
|
deltamethrin
|
x
|
x
|
x
|
x
|
x
|
|
Delta EW 50
|
deltamethrin
|
x
|
x
|
x
|
x
|
x
|
|
Decis Protech
|
deltamethrin
|
x
|
x
|
x
|
x
|
x
|
|
Proteus 110 OD
|
deltamethrin + thiacloprid
|
x
|
x
|
x
|
x
|
|
|
Trebon 10 F
|
ethofenprox
|
x
|
||||
|
Nexide, Rapid
|
gamma-cyhalothrin
|
x
|
x
|
x
|
x
|
x
|
|
Reldan 22
|
Chlorpyriphos-methyl
|
x
|
||||
|
Kaiso Sorbie
|
lambda-cyhalothrin
|
x
|
x
|
x
|
||
|
Karate Zeon 5 CS
|
lambda-cyhalothrin
|
x
|
x
|
x
|
x
|
x
|
|
Pyrinex 25 CS
|
chlorpyriphos
|
x
|
x
|
|||
|
Mavrik 2 F
|
tau-fluvalinate
|
x
|
||||
|
Biscaya 240 OD
|
thiacloprid
|
x
|
x
|
x
|
x
|
x
|
|
Calypso 480 SC
|
thiacloprid
|
x
|
x
|
x
|
||
|
Fury 10 EW
|
zeta- cypermethrin
|
x
|
x
|
x
|
x
|
x
|
|
Markate 50
|
lambda-cyhalothrin
|
x
|
x
|
x
|
||
|
Nurelle Max
|
cypermethrin + chlorpyrifos
|
x
|
x
|
|||
Další články v kategorii Ochrana obecně











 RSS
RSS RSS
RSS